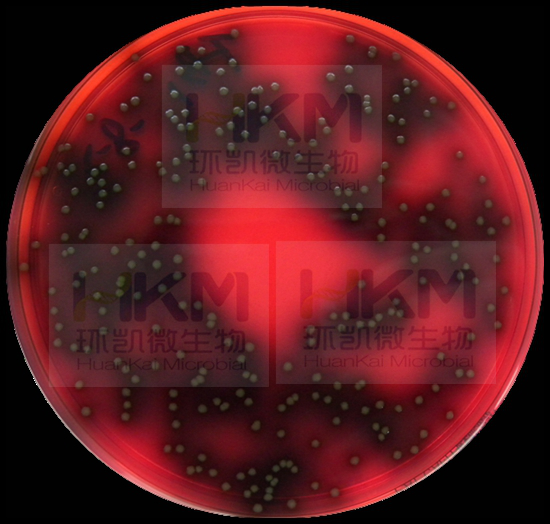

单核细胞增生李斯特氏菌检验解决方案
发布时间:2022-07-26 浏览次数:9311 分享:
单核细胞增生李斯特氏菌是一种人畜共患病的病原菌。它能引起人畜的李氏菌的病,感染后主要表现为败血症、脑膜炎和单核细胞增多。它广泛存在于自然界中,食品中存在的单增李氏菌对人类的安全具有危险,该菌在4℃的环境中仍可生长繁殖,是冷藏食品威胁人类健康的主要病原菌之一,因此,在食品卫生微生物检验中,必须加以重视。
一、生物学特性
1、形态与染色
该菌为革兰氏阳性短杆菌,大小约为0.5μmх1.0-2.0μm,直或稍弯,两端钝圆,常呈V字型排列,偶有球状、双球状,兼性厌氧、无芽胞,一般不形成荚膜,但在营养丰富的环境中可形成荚膜,在陈旧培养中的菌体可呈丝状及革兰氏阴性,该菌有4根周毛和1根端毛,但周毛易脱落。
2、培养特性
该菌营养要求不高,在20--25℃培养有动力,穿刺培养2-5天可见倒立伞状生长,肉汤培养物在显微镜下可见翻跟斗运动。该菌的生长范围为2--42℃(也有报道在0℃能缓慢生长),最适培养温度为35--37℃,在pH中性至弱碱性(pH9.6)、氧分压略低、二氧化碳张力略高的条件下该菌生长良好,在pH3.8 - PH4.4能缓慢生长,在6.5% NaCl 肉汤中生长良好。在固体培养基上,菌落初始很小,透明,边缘整齐,呈露滴状,但随着菌落的增大,变得不透明。在5-7%的血平板上,菌落通常也不大,灰白色,刺种血平板培养后可产生窄小的β-溶血环。在0.6%酵母浸膏胰酪大豆琼脂(TSAYE)和改良Mc Bride(MMA)琼脂上,用450角入射光照射菌落,通过解剖镜垂直观察,菌落呈兰色、灰色或兰灰色。
3、生化反应
该菌触酶阳性,氧化酶阴性,能发酵多种糖类,产酸不产气,如发酵葡萄糖、乳糖、水杨素、麦芽糖、鼠李糖、七叶苷、蔗糖(迟发酵)、山梨醇、海藻糖、果糖,不发酵木糖、甘露醇、肌醇、阿拉伯糖、侧金盏花醇、棉子糖、卫矛醇和纤维二糖,不利用枸橼酸盐,40%胆汁不溶解,吲哚、硫化氢、尿素、明胶液化、硝酸盐还原、赖氨酸、鸟氨酸均阴性,VP、甲基红试验和精氨酸水解阳性。
二、检验

1. 增菌培养
以无菌操作取样品25g(mL)加入到含有225mL LB1 增菌液的均质袋中,在拍击式均质器上连续均质1min~2min;或放入盛有225mL LB1 增菌液的均质杯中,以8000r/min~10000r/min均质1min~2min。于30℃±1℃培养24h±2h,移取0.1mL,转种于10mL LB2 增菌液内,于30 ℃±1℃ 培养24h±2h。
2. 分离
取LB2 二次增菌液划线接种于李斯特氏菌显色平板和PALCAM 琼脂平板,于36 ℃±1 ℃培养24h~48h,观察各个平板上生长的菌落。典型菌落在PALCAM 琼脂平板上为小的圆形灰绿色菌落,周围有棕黑色水解圈,有些菌落有黑色凹陷(图1);在李斯特氏菌显色平板上的菌落特征(图2),参照产品说明进行判定。

图1 PALCAM 琼脂平板上的典型菌落 图2 李斯特显色培养基平板上典型菌落
3. 初筛
自选择性琼脂平板上分别挑取3个~5个典型或可疑菌落,分别接种木糖、鼠李糖发酵管,于36℃±1℃ 培养24h±2h,同时在TSA-YE平板上划线,于36℃±1℃培养18h~24h,然后选择木糖阴性、鼠李糖阳性的纯培养物继续进行鉴定。
4. 鉴定(或选择生化鉴定试剂盒或全自动微生物鉴定系统等)
4.1 染色镜检:
李斯特氏菌为革兰氏阳性短杆菌(图3),大小为(0.4μm~0.5μm)×(0.5μm~2.0μm);用生理盐水制成菌悬液,在油镜或相差显微镜下观察,该菌出现轻微旋转或翻滚样的运动。


图四、革兰氏阳性短杆菌 图五、动力试验:伞状生长
4.2 动力试验:
挑取纯培养的单个可疑菌落穿刺半固体或SIM 动力培养基,于25 ℃~30 ℃培养48h,李斯特氏菌有动力,在半固体或SIM 培养基上方呈伞状生长(图4),如伞状生长不明显,可继续培养5d,再观察结果。
4.3 生化鉴定: 挑取纯培养的单个可疑菌落,进行过氧化氢酶试验,过氧化氢酶阳性反应的菌落可选择HK-MID李斯特氏菌生化鉴定系统进行生化鉴定。


5. 小鼠毒力试验
将分离的菌株接种到10 mL TSBYE肉汤中,35℃培养24h,将培养物离心、浓缩,用1mL生理盐水制成菌悬液(浓度为1010个菌/mL),取0.1mL腹腔注射体重为16-18g 小鼠,每组5个观察7d内小鼠死亡情况。用已知致病的单增李斯特氏菌和非致病的英诺克李斯特氏菌相同方法进行,做对照试验。
三、控制
单增李斯特氏菌在一般热加工处理中能存活,热处理已杀灭了竞争性细菌群,使单增李斯特氏菌在没有竞争的环境条件下易于存活,所以在食品加工中,中心温度必须达到70℃持续2分钟以上。
单增李斯特氏菌在自然界中广泛存在,所以即使产品已经过热加工处理充分灭活了单增李斯特氏菌,但有可能造成产品的二次污染,因此蒸煮后防止二次污染是极为重要的。
由于单增李斯特氏菌在4℃下仍然能生长繁殖,所以未加热的冰箱食品增加了食物中毒的危险。冰箱食品需加热后再食用。






